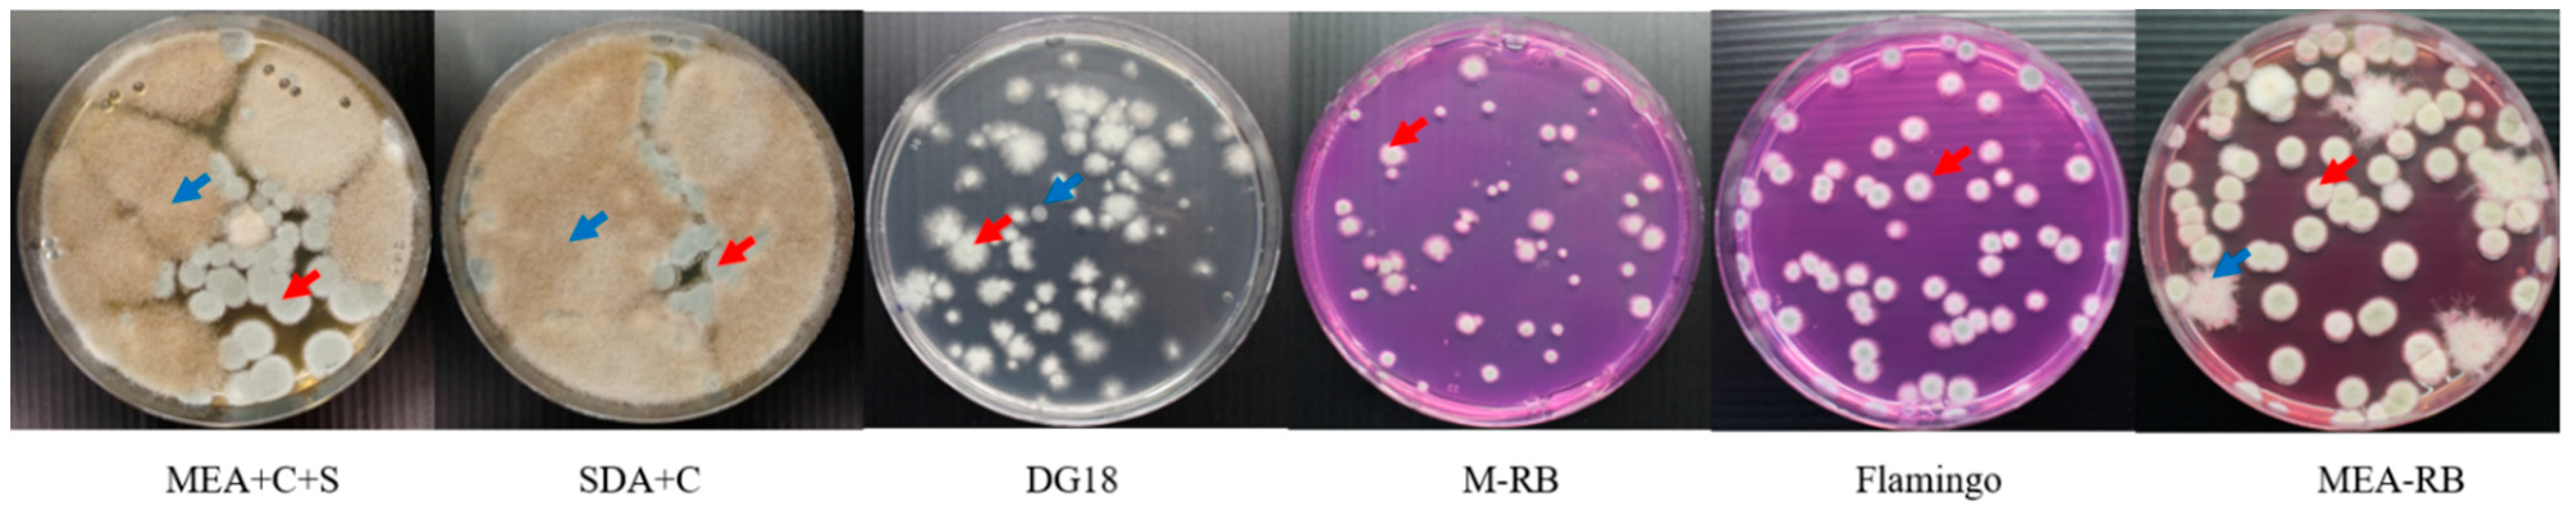
Microorganisms 09 01155 g002 Microorganisms 09 01155 g002
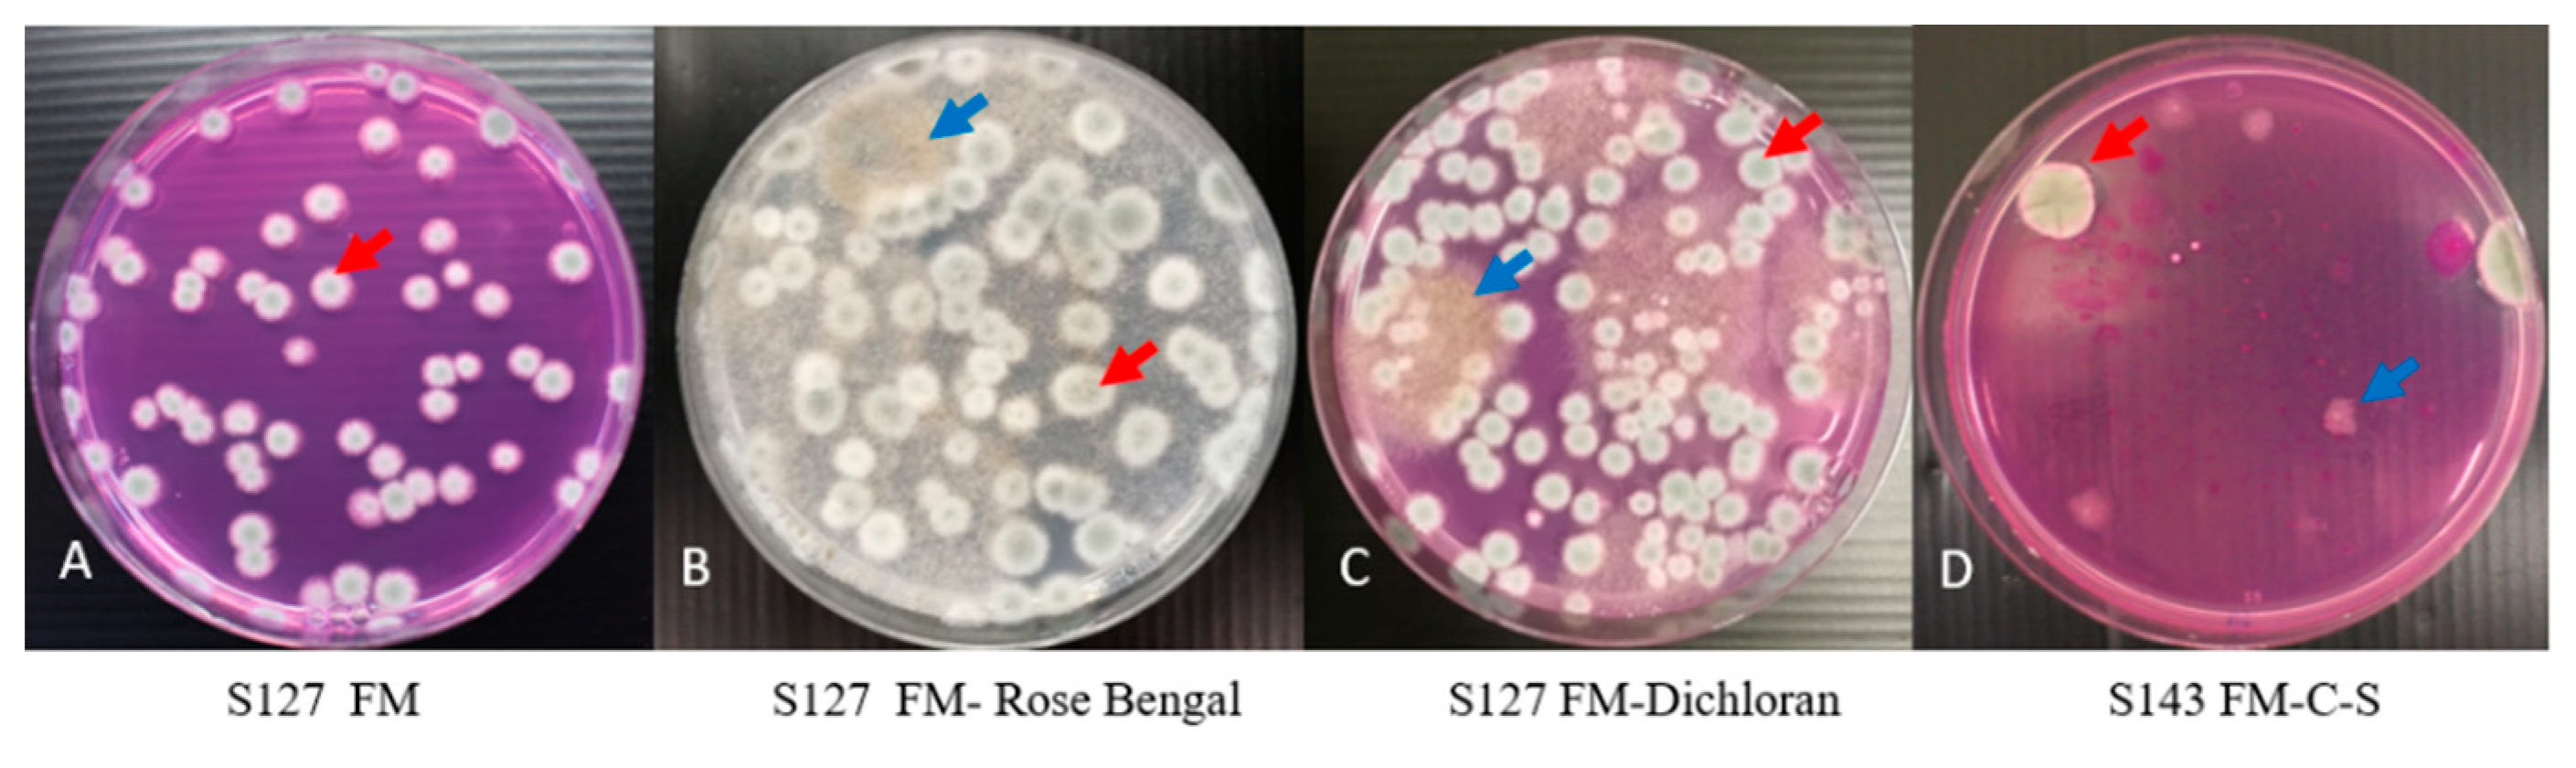
Microorganisms 09 01155 g003 Microorganisms 09 01155 g003
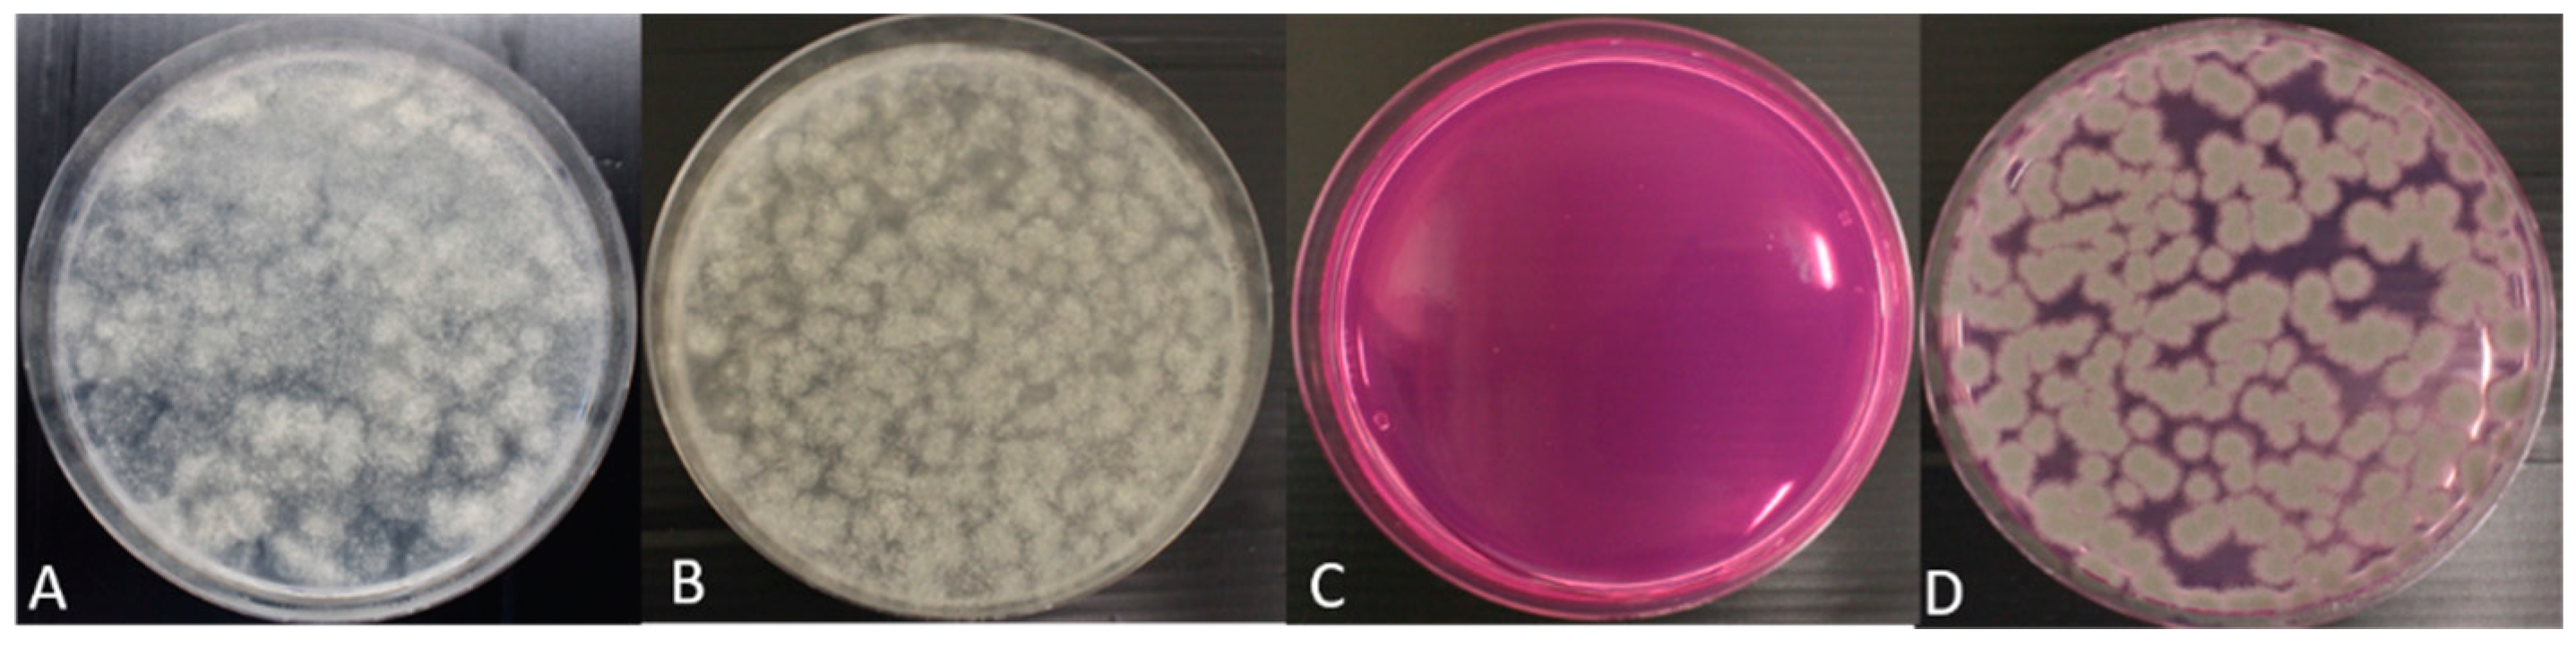
Microorganisms 09 01155 g004 Microorganisms 09 01155 g004

Selective Flamingo Medium for the Isolation of Aspergillus fumigatus
Abstract
1. Introduction
2. Materials and Methods
2.1. Media Preparation
2.2. Isolating A. fumigatus Using Various Media
2.3. Validation of Flamingo Medium
3. Results
3.1. Flamingo Medium Is Highly Effective for the Isolation of A. fumigatus
3.2. Flamingo Medium Allows Rapid Growth for a Range of Genotypes of A. fumigatus
3.3. RB and Dichloran Are Key Components in Flamingo Medium
3.4. The Validation of Flamingo Medium for Isolating Clinical A. fumigatus from an Artificial Mixture of Clinical Isolates of A. fumigatus and Mucorales
4. Discussion
Supplementary Materials
Author Contributions
Funding
Institutional Review Board Statement
Informed Consent Statement
Acknowledgments
Conflicts of Interest
Appendix A

Appendix B

Appendix C

Appendix D
| # A. fum Colonies on MEA Medium | # A. fum Colonies on Flamingo Medium | Significance Test (Pairwise t-Test) | |
|---|---|---|---|
| Environmental mixed population Mucor-free S56 | 47 ± 5 | 50 ± 6 | p > 0.05 |
| Environmental mixed population Mucor-free S81 | 156 ± 7 | 139 ± 17 | p > 0.05 |
| Environmental mixed population Mucor-free S72 | 86 ± 3 | 81 ± 2 | p > 0.05 |
| Mixture of TR34/L98H, WT, TR46/Y121F/T289A | 75 ± 5 | 79 ± 3 | p > 0.05 |
| Environmental WT (81-4) | 65 ± 3 | 61 ± 3 | p > 0.05 |
| Environmental TR34/L98H (66-3) | 73 ± 4 | 76 ± 6 | p > 0.05 |
| Environmental isolate TR343/L98H (30-40-1) | 80 ± 4 | 84 ± 3 | p > 0.05 |
| Environmental TR46/Y121F/T289A (50-32) | 69 ± 7 | 66 ± 4 | p > 0.05 |
| Environmental isolate TR463/Y121F/T289A (70-28) | 75 ± 6 | 69 ± 5 | p > 0.05 |
| Environmental isolate TR464/Y121F/T289A (39-2) | 86 ± 5 | 83 ± 3 | p > 0.05 |
| Environmental resistant isolate without tandem repeats (72-8) | 96 ± 5 | 92 ± 5 | p > 0.05 |
References
- Verweij, P.E.; Snelders, E.; Kema, G.H.; Mellado, E.; Melchers, W.J. Azole resistance in Aspergillus fumigatus: A side-effect of environmental fungicide use? Lancet Infect. Dis. 2009, 9, 789–795. [Google Scholar] [CrossRef]
- Lestrade, P.P.A.; Buil, J.B.; van der Beek, M.T.; Kuijper, E.J.; van Dijk, K.; Kampinga, G.; Rijnders, B.J.A.; Vonk, A.; de Greef, S.C.; Schoffelen, A.F.; et al. Paradoxal trends in azole-resistant Aspergillus fumigatus in a national multicenter surveillance program, The Netherlands, 2013–2018. Emerg. Infect. Dis. 2020, 26, 1447–1455. [Google Scholar] [CrossRef]
- Verweij, P.E.; Chowdhary, A.; Melchers, W.J.G.; Meis, J.F. Azole Resistance inAspergillus fumigatus: Can We Retain the Clinical Use of Mold-Active Antifungal Azoles? Clin. Infect. Dis. 2016, 62, 362–368. [Google Scholar] [CrossRef]
- Buil, J.B.; Hare, R.K.; Zwaan, B.J.; Arendrup, M.C.; Melchers, W.J.G.; Verweij, P.E. The fading boundaries between patient and environmental routes of triazole resistance selection in Aspergillus fumigatus. PLoS Pathog. 2019, 15, e1007858. [Google Scholar] [CrossRef] [PubMed]
- Lestrade, P.P.; Bentvelsen, R.G.; Schauwvlieghe, A.F.A.D.; Schalekamp, S.; van der Velden, W.J.; Kuiper, E.J.; van Paassen, J.; van der Hoven, B.; van der Lee, H.A.; Melchers, W.J.; et al. Voriconazole resistance and mortality in invasive aspergillosis: A multicenter retrospective cohort study. Clin. Infect. Dis 2019, 68, 1463–1471. [Google Scholar] [CrossRef] [PubMed]
- Schoustra, S.E.; Debets, A.J.; Rijs, A.J.; Zhang, J.; Snelders, E.; Leendertse, P.C.; Melchers, W.J.; Rietveld, A.G.; Zwaan, B.J.; Verweij, P.E. Environmental hotspots for azole resistance selection of Aspergillus fumigatus, The Netherlands. Emerg. Infect. Dis. 2019, 25, 1347. [Google Scholar] [CrossRef] [PubMed]
- Snelders, E.; Camps, S.M.; Karawajczyk, A.; Schaftenaar, G.; Kema, G.H.; van der Lee, H.A.; Klaassen, C.H.; Melchers, W.J.; Verweij, P.E. Triazole fungicides can induce cross-resistance to medical triazoles in Aspergillus fumigatus. PLoS ONE 2012, 7, e31801. [Google Scholar] [CrossRef] [PubMed]
- Zhang, J.; Van Den Heuvel, J.; Debets, A.J.; Verweij, P.E.; Melchers, W.J.; Zwaan, B.J.; Schoustra, S.E. Evolution of cross-resistance to medical triazoles in Aspergillus fumigatus through selection pressure of environmental fungicides. Proc. Biol. Sci. 2017, 284, 20170635. [Google Scholar] [CrossRef] [PubMed]
- Chowdhary, A.; Kathuria, S.; Xu, J.; Meis, J.F. Emergence of azole-resistant Aspergillus fumigatus strains due to agricultural azole use creates an increasing threat to human health. PLoS Pathog. 2013, 9, e1003633. [Google Scholar] [CrossRef]
- Rybak, J.M.; Fortwendel, J.R.; Rogers, P.D. Emerging threat of triazole-resistant Aspergillus fumigatus. J. Antimicrob. Chemother. 2019, 74, 835–842. [Google Scholar] [CrossRef]
- Zhang, J.; Snelders, E.; Zwaan, B.J.; Schoustra, S.E.; Meis, J.F.; Van Dijk, K.; Hagen, F.; Van Der Beek, M.T.; Kampinga, G.A.; Zoll, J. A novel environmental azole resistance mutation in Aspergillus fumigatus and a possible role of sexual reproduction in its emergence. mBio 2017, 8, e00791-17. [Google Scholar] [CrossRef]
- Kang, S.E.; Sumabat, L.G.; Melie, T.; Mangum, B.; Momany, M.; Brewer, M.T. Evidence for the agricultural origin of antimicrobial resistance in a fungal pathogen of humans. bioRxiv 2020. [Google Scholar] [CrossRef]
- Barber, A.E.; Riedel, J.; Sae-Ong, T.; Kang, K.; Brabetz, W.; Panagiotou, G.; Deising, H.B.; Kurzai, O. Effects of agricultural fungicide use on Aspergillus fumigatus abundance, antifungal susceptibility, and population structure. mBio 2020, 11, e02213-20. [Google Scholar] [CrossRef]
- Viegas, C.; Almeida, B.; Aranha Caetano, L.; Afanou, A.; Straumfors, A.; Veríssimo, C.; Gonçalves, P.; Sabino, R. Algorithm to assess the presence of Aspergillus fumigatus resistant strains: The case of Norwegian sawmills. Int. J. Environ. Health Res. 2020, 8, 1–9. [Google Scholar] [CrossRef]
- Siopi, M.; Rivero-Menendez, O.; Gkotsis, G.; Panara, A.; Thomaidis, N.S.; Alastruey-Izquierdo, A.; Pournaras, S.; Meletiadis, J. Nationwide surveillance of azole-resistant Aspergillus fumigatus environmental isolates in Greece: Detection of pan-azole resistance associated with the TR46/Y121F/T289A cyp51A mutation. J. Antimicrob. Chemother. 2020, 75, 3181–3188. [Google Scholar] [CrossRef]
- Engel, T.G.P.; Tehupeiory-Kooreman, M.; Melchers, W.J.G.; Reijers, M.H.; Merkus, P.; Verweij, P.E. Evaluation of a new culture protocol for enhancing fungal detection rates in respiratory samples of cystic fibrosis patients. J. Fungi 2020, 6, 82. [Google Scholar] [CrossRef] [PubMed]
- de Hoog, G.S.; Guarro, J.; Gené, J.; Figueras, M. Atlas of Clinical Fungi; Centraalbureau voor Schimmelcultures (CBS): Hilversum, The Netherlands, 2000. [Google Scholar]
- Larone, D. Part II: Detailed Description. Medically Important Fungi: A Guide to Identification, 3rd ed.; ASM Press: Washington, DC, USA, 1995. [Google Scholar]
- Richardson, M.D.; Rautemaa-Richardson, R. Biotic environments supporting the persistence of clinically relevant Mucormycetes. J. Fungi 2019, 6, 4. [Google Scholar] [CrossRef]
- Zhang, J.; Lopez Jimenez, L.; Snelders, E.; Debets, A.J.M.; Rietveld, A.G.; Zwaan, B.J.; Verweij, P.E.; Schoustra, S.E. Dynamics of aspergillus fumigatus in azole fungicide-containing plant waste in The Netherlands (2016–2017). Appl. Environ. Microbiol. 2021, 87. [Google Scholar] [CrossRef]
- Cotty, P.J. Comparison of four media for the isolation of Aspergillus flavus group fungi. Mycopathologia 1994, 125, 157–162. [Google Scholar] [CrossRef] [PubMed]
- Leendertse, P.C.; Gommer, R.; van Beek Culemborg, J. Groen-en houtafval als bron van azolen-resistente schimmel, deel A: Deskstudie. CLM-Rapport 1065 2021, in press. [Google Scholar]
- Gutarowska, B.; Piotrowska, M. Methods of mycological analysis in buildings. Build. Environ. 2007, 42, 1843–1850. [Google Scholar] [CrossRef]
- Henson, O.E. Dichloran as an inhibitor of mold spreading in fungal plating media: Effects on colony diameter and enumeration. Appl. Environ. Microbiol. 1981, 42, 656–660. [Google Scholar] [CrossRef] [PubMed]
- Richardson, J.P.; Naglik, J.R. Special issue: Mucosal fungal infections. J. Fungi 2018, 4, 43. [Google Scholar] [CrossRef] [PubMed]

Publisher’s Note: MDPI stays neutral with regard to jurisdictional claims in published maps and institutional affiliations. |
© 2021 by the authors. Licensee MDPI, Basel, Switzerland. This article is an open access article distributed under the terms and conditions of the Creative Commons Attribution (CC BY) license (https://creativecommons.org/licenses/by/4.0/).
Share and Cite
Zhang, J.; Debets, A.J.M.; Verweij, P.E.; Schoustra, S.E. Selective Flamingo Medium for the Isolation of Aspergillus fumigatus. Microorganisms 2021, 9, 1155. https://doi.org/10.3390/microorganisms9061155
Zhang J, Debets AJM, Verweij PE, Schoustra SE. Selective Flamingo Medium for the Isolation of Aspergillus fumigatus. Microorganisms. 2021; 9(6):1155. https://doi.org/10.3390/microorganisms9061155
Chicago/Turabian StyleZhang, Jianhua, Alfons J. M. Debets, Paul E. Verweij, and Sijmen E. Schoustra. 2021. "Selective Flamingo Medium for the Isolation of Aspergillus fumigatus" Microorganisms 9, no. 6: 1155. https://doi.org/10.3390/microorganisms9061155
APA StyleZhang, J., Debets, A. J. M., Verweij, P. E., & Schoustra, S. E. (2021). Selective Flamingo Medium for the Isolation of Aspergillus fumigatus. Microorganisms, 9(6), 1155. https://doi.org/10.3390/microorganisms9061155

